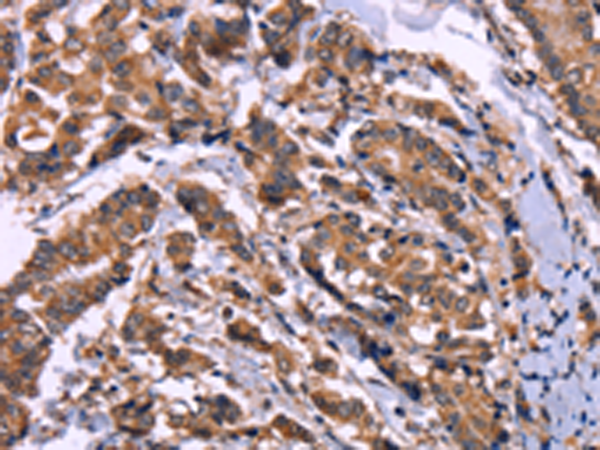

-
分类: 科研抗体货号: P00893别名: CDG1L; DIBD1; LOH11CR1J应用: WB,IHC反应种属: Human, Mouse
-
分类: 科研抗体货号: P00918别名: AMPK; AMPK2; PRKAA; AMPKa2应用: IHC反应种属: Human, Mouse, Rat
-
分类: 科研抗体货号: P00935别名: APG10; APG10L; pp12616应用: WB,IHC反应种属: Human, Mouse
-
分类: 科研抗体货号: P00892别名: CDG1H应用: IHC反应种属: Human, Mouse
-
分类: 科研抗体货号: P00915别名: ALI1; DEGA; AMIGO-2应用: WB,IHC反应种属: Human, Mouse, Rat
-
分类: 科研抗体货号: P00934别名: SWM1; APC13应用: WB反应种属: Human, Mouse
-
分类: 科研抗体货号: P00970别名: Spir-2应用: IHC反应种属: Human
-
分类: 科研抗体货号: P00914别名: AMHR; MRII; MISR2; MISRII应用: IHC反应种属: Human, Mouse, Rat
-
分类: 科研抗体货号: P00931别名: APC2; RP11-350O14.5应用: IHC反应种属: Human, Mouse
-
分类: 科研抗体货号: P00969别名: DNMT3A2; M.HsaIIIA应用: IHC反应种属: Human, Mouse, Rat

鄂公网安备42018502007531号
鄂公网安备42018502007531号

